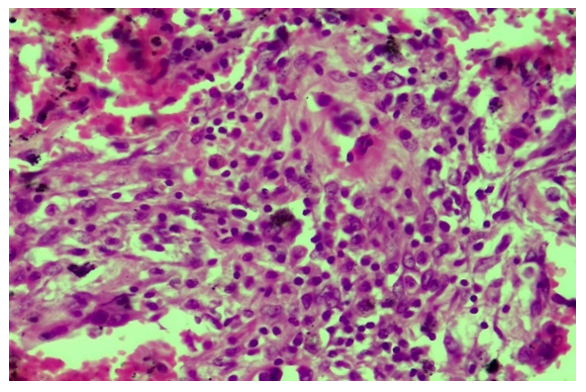

Murotov Khabibulla Abulkasimovich
Department of Pathological Anatomy and Forensic Medicine of the Center for the Development of Professional Qualifications of Medical Workers, Uzbekistan
Correspondence to: Murotov Khabibulla Abulkasimovich, Department of Pathological Anatomy and Forensic Medicine of the Center for the Development of Professional Qualifications of Medical Workers, Uzbekistan.
Copyright © 2024 The Author(s). Published by Scientific & Academic Publishing.
This work is licensed under the Creative Commons Attribution International License (CC BY).
http://creativecommons.org/licenses/by/4.0/

Abstract
In this article, the morphological changes in the walls of pulmonary blood vessels caused by the infection of COVID-19 are studied. During the pandemic of 2021, fragments of the lungs of people who died from this disease were taken from the areas rich in blood vessels and studied histologically. It is known that the abundance of ACE2 enzyme in the endothelium of pulmonary blood vessels, their extensive damage by SARS-CoV-2, the development of a strong and scattered discirculation process, which continues with the appearance of endotheliosis, endothelitis, coagulopathy, vasculitis, microvasculitis thrombi, leads to the development of diffuse hemorrhagic inflammation in the lung tissue. Initially, all the blood vessels of the lung tissue are suddenly filled, the diapedesis continues with the development of hemorrhages and hemorrhagic edema in the alveoli. The development of fibrinoid swelling and fibrinoid necrosis endotheliitis in the walls of the pulmonary blood vessels, the appearance of thrombus in both large and small vessels, manifested by the development of macro- and microangiopathy. it is observed that During the proliferative period of COVID-19, lympho-histiocytic infiltration, and finally sclerosing, are detected in and around the walls of blood vessels, then in the walls of alveoli.
Keywords:
COVID-19, Lungs, Blood vessels, Fibrinoid necrosis, Thrombosis, Microangiopathy, Hemorrhage
Cite this paper: Murotov Khabibulla Abulkasimovich, Pathomorphology of Pulmonary Blood Vessels in COVID-19, American Journal of Medicine and Medical Sciences, Vol. 14 No. 1, 2024, pp. 37-41. doi: 10.5923/j.ajmms.20241401.09.
1. Introduction
The pathogenesis, morphogenesis, and pathomorphology of vascular injury in COVID-19 is the fundamental basis of lung injury. It is known that the SARS-CoV-2 virus has a tropism against the vascular endothelium without having a cytopathic effect on various types of cells, which aggravates alveolar tissue damage [1,2,3,4]. In the studies conducted in 2020-2022, microscopic changes in pulmonary vascular lesions were mainly studied. At the same time, issues of local and systemic damage of blood vessels, microangiopathy, vasculitis and endotheliitis are being discussed, and questions about the mechanism of their development remain open. The mechanisms of microthrombi formation under the influence of new coronavirus infection have not been fully studied [5,6,7,8]. In the future pathologo-anatomical studies, the use of histological, histochemical, and immunohistochemical methods may reveal the causes of neoangiogenesis in different periods of infection, as well as the study of alterative, inflammatory, and reparative processes in the walls of blood vessels. According to the literature, thrombi appear in almost all branches of the pulmonary artery, including segmental, segmental, subsegmental, and microcirculatory veins [9,10,11]. The main part of the pulmonary artery is damaged in 13.5% of cases, and its middle and small branches are damaged in 100% of cases. Due to the thickening of the walls of blood vessels due to swelling and inflammation under the influence of coronavirus, the destruction and necrosis of the lung tissue increases. Hypoxia developed as a result of impaired vascular perfusion leads to the activation of endothelium and platelets, as a result of which pathological factors increase. In addition, inflammatory cytokines disrupt the integrity of the endothelium and lead to the development of microangiopathy.The aim: Elucidation of information on the morphogenesis and characteristic changes of the pathomorphological changes that develop in the arteries and microcirculatory vessels of the lung tissue during the periods of COVID-19.
2. Material and Methods
As a research material, 28 of those who died of pneumonia caused by the coronavirus during the pandemic period of August-September 2021 were dissected and examined by the autopsy method at the Republican Pathological Anatomy Center. During the autopsy, samples were taken from all internal organs, including the lungs, for histological examination. The sections were processed in the usual way and paraffin blocks were prepared. Histological sections were taken from it and stained with hematoxylin and eosin. It was studied under a light microscope and the necessary areas were photographed. For the preparation of this article, histological sections from the lungs were studied in 10, 20, 40 objects of a light microscope, and microphotographs were taken that show the most significant pathomorphological changes that develop in the blood vessels of the lung tissue under the influence of the coronavirus.
3. Results and Discussion
COVID-19 infection is an acute infection caused by a coronavirus, the causative agent of which is the SARS-CoV-2 ACE2 enzyme, which has a cytotoxic effect on all existing cells, including most cells of the lung tissue. The abundance of the ACE2 enzyme in the endothelium of pulmonary blood vessels continues with the development of a strong and scattered discirculation process, which continues with their extensive damage, endotheliosis, endotheliitis, coagulopathy, the formation of blood clots, vasculitis, microvasculitis. Coagulopathy in the form of microangiopathy and microthrombi leads to bleeding from almost all blood vessels and develops diffuse hemorrhagic inflammation in lung tissue. When the lungs of those who died from the infection of COVID-19 were studied morphologically, the following changes were found. It is determined that all the blood vessels of the lungs, including pulmonary artery branches, bronchial artery branches, and pulmonary vein branches, are almost equally expanded, filled with blood, blood is poured around the small blood vessels, and the wall of the alveolar space is thickened due to scattered and diffuse hemorrhage. When studied under the microscope lens, it is observed that all the capillaries in the wall of the alveolar space have expanded sharply, almost all of them have been surrounded by diapedesis (Fig. 1). | Figure 1. The capillaries of the alveolar walls are full, blood is poured around them. Stain: H-E. size: 10x40 |
In the first exudative period of COVID-19 infection, when all the bronchioles and alveolar cavities are filled with serous-hemorrhagic exudate, the pulmonary artery's thick branches are sharply expanded, its wall is thinned, a perivascular tumor center appears around it, the blood rheology in its cavity is disturbed, and blood cells, including erythrocytes, are located in a disorderly manner. is determined. It is found that fibrin thrombus has appeared in some of the large branches of the pulmonary artery.It is determined that the composition of the thrombus consists mainly of fibrin with a fibrous and coarse homogenous appearance, in its central part it is thinned and vacuolated foci are formed, and white blood cells and pigments are located in such foci (Fig. 2). One side surface of this thrombus is observed to stick to the blood vessel wall. The wall of the vessel is thinned, some places are hardened, the staining is reduced, strong edema has developed around the vessel. When the small blood vessels of the lungs are carefully studied under the microscope lens, it is determined that fibrin clots appear in their cavity. In the case of COVID-19 infection, as a result of the development of a strong and scattered discirculation process, which continues with diffuse damage to the blood vessels of the lungs, endotheliosis, endotheliitis, coagulopathy, the formation of blood clots, vasculitis, microvasculitis, serous-hemorrhagic-fibrinous exudate accumulates in the alveolar tissue of the lung, and the alveolar tissue becomes deventilated. thickens, the first period of croupous pneumonia is similar to the period of blood transfusion, and red jaundice develops. | Figure 2. A fibrin thrombus has appeared in the large branch of the pulmonary artery, and the presence of thrombus in the capillaries. Stain: H-E. size: 10x10 |
Microscopically, it is determined that distelectase has developed and thickened diffusely in the lung alveolar tissue, that is, the cavity and wall of the alveoli are not differentiated, and have become a single airless tissue. In this case, all the branches of the pulmonary artery are enlarged, full, blood is poured around it.During the proliferative period of the COVID-19 infection, initial changes are observed in the blood vessel wall. Vascular endothelium is desquamated, hypertrophied and atrophied due to endotheliosis and endotheliitis, and the basal membrane is exposed. Due to the development of the process of disorganization in the basal membrane, it is determined that fibrinoid bending and fibrinoid necrosis have occurred, it has become homogenized, some areas have hyperchromasia, and it is destroyed. The pericyte cells around the vessel wall are activated and proliferated, their nuclei become hypertrophied and hyperchromic. It is observed that scattered lymphoid infiltration appeared around the vessel and in the wall tissue between the alveoli (Fig. 3). Fibrinoid swelling and fibrinoid necrosis are also found in the fibrous structures of the alveolar wall. | Figure 3. Proliferation of lymphohistiocytic cells in the walls of pulmonary blood vessels and alveoli during the proliferative period of COVID-19. Stain: H-E. size: 10x40 |
As a result of the infection of COVID-19, the pathomorphological changes developed in the wall of the pulmonary blood vessels deepen, all layers of the vessel wall are destroyed, the vessel loses its shape, the cavity narrows, and fragments of endothelium, basement membrane, and even pericyte cells fall into it. In this case, it is determined that a thrombus has definitely appeared in the cavity of the destroyed blood vessel, and in this case, a fibrinous thrombus has appeared in a mesh pattern.A strong lymphoid and macrophage infiltration is found around the vessel. Another pathomorphological fact is that during the transition from the exudative period to the proliferative period of COVID-19 infection, a fibrinous mass appears in the lung tissue, that is, in the alveolar space, and a fibrinous thrombus appears in the blood vessels. In this case, the alveolar tissue of the lung has completely lost its histotopography, alveoli and bronchioles cannot be identified, a fibrinous mass has accumulated in the tissue without a complete structure, and the presence of a fibrinous thrombus in the space of blood vessels is determined (Fig. 4). The unstructured lung tissue is found to be diffusely infiltrated with lymphoid and histiocytic cells. | Figure 4. Pulmonary tissue became disorganized, fibrinous mass and fibrin thrombus appeared in blood vessels. Stain: H-E. size: 10x40 |
During the second proliferation period of the COVID-19 infection, the proliferation of lymphohistiocytic cells is observed between the walls of blood vessels and alveoli in the lung tissue. In this case, it is determined that the walls of both the pulmonary artery and bronchial artery branches of almost all diameters are sharply thickened, and there are special cells of the vessel wall and lymphoid infiltration (Fig. 8). However, due to the state of swelling and mucoid swelling of the vessel wall, which has undergone this type of proliferative process, it is determined that diffuse diapedesis hemorrhage has developed in its composition. This is confirmed by the fact that the blood in the vessel cavity, that is, part of the erythrocytes is adhered to the inner surface of the wall. It is observed that the wall of the alveoli is diffusely infiltrated with lympho-histiocytic cells, thickened and deformed, and diffusely filled with erythrocytes. During the proliferative period of the infection of COVID-19, it is known that the proliferation of lympho-histiocytic cells predominates in and around the walls of blood vessels. It is observed that the wall of some blood vessels is destroyed, a fibrinous and cellular thrombus appears in its cavity, and the fibrous structures of the basement membrane undergo mucoid and fibrinoid swelling and spread to the surrounding tissue. It is observed that the wall of some blood vessels is destroyed, a fibrinous and cellular thrombus appears in its cavity, and the fibrous structures of the basement membrane undergo mucoid and fibrinoid swelling and spread to the surrounding tissue. It is determined that an infiltrate consisting of mainly lymphoid and macrophage cells has appeared around this blood vessel (Fig. 5). It is found that more histiocytic cells are proliferated and occupy a large area in and around the wall of other vessels. It is determined that the infiltration of histiocytic cells surrounds the blood vessels in the form of tufts and spreads to the alveolar tissue (Fig 6). During the proliferative period of the disease, layer-by-layer structures are formed due to the proliferation of both cells and fibrous structures directly on the wall of blood vessels, and it is determined that the vessel wall is thickened. In this case, it is observed that the inner endothelium layer has completely migrated, the basement membrane has become wrinkled and deformed, several tufts have appeared, several muscle tufts have appeared from the proliferation of smooth muscle cells in the muscle layer (Fig. 7). | Figure 5. Infiltration of lymphoid and macrophage cells around blood vessels during the proliferative period of COVID-19. Paint: H-E. Size: 10x40 |
 | Figure 6. During the proliferative period of COVID-19, cluster proliferation of histiocytic cells in the vascular periphery and alveolar interstitial tissue. Paint: H-E. Size: 10x20 |
 | Figure 7. It was manifested by the thickening of the vascular wall, the appearance of several basement membrane and muscular layers. V.G. Staining. Size 20x10 |
 | Figure 8. Sclerosis, carnification of connective tissue in blood vessels and alveolar tissue.V.G. Staining. Size 20x10 |
An infiltrate of lymphoid and histiocytic cells is found in the outer adventitial layerThe abundance of ACE2 enzyme in the endothelium of pulmonary blood vessels, their extensive damage by SARS-CoV-2, the development of a strong and scattered discirculation process, which continues with the appearance of endotheliosis, endotheliitis, coagulopathy, vasculitis, microvasculitis blood clots, leads to the development of diffuse hemorrhagic inflammation in the lung tissue.It is observed that fibrinoid thickening and fibrinoid necrosis and development of endotheliitis in the wall of pulmonary blood vessels are manifested by the appearance of thrombus in both large and small vessels and the development of macro- and microangiopathy.During the proliferative period of COVID-19, lympho-histiocytic infiltration, and finally sclerosing, are detected in and around the walls of blood vessels, then in the walls of alveoli.
4. Conclusions
1. Changes in the lungs during COVID-19 infection proceed in several stages: in the first stage, all the blood vessels of the lung tissue are suddenly filled, leading to the development of diffuse hemorrhagic inflammation due to diapedesis hemorrhages and hemorrhage in the alveoli.2. In the exudative stage, the development of fibrinoid swelling and fibrinoid necrosis and endotheliitis in the wall of pulmonary blood vessels is manifested by the appearance of thrombus in both large and small vessels and the development of macro- and microangiopathy.3. During the proliferative period of COVID-19, lympho-histiocytic infiltration, and finally sclerosing, are found in and around the walls of blood vessels, then in the walls of alveoli.
References
| [1] | Malas M, Naazie I, Elsayed N, et al. Thromboembolism risk of COVID-19 is high and associated with a higher risk of mortality: A systematic review and meta-analysis. E clinical medicine. 2020; 29: 100639. https://doi.org/10.1016/j.eclinm.2020.100639. |
| [2] | Jimenez D, Garda-Sanchez A, Rali Pet al. Incidence of VTE and Bleeding Among Hospitalized Patients With Coronavirus Disease 2019. Chest. 2021; 159(3): 1182-96. https://doi.org/10.1016/j.chest.2020.11.005. |
| [3] | Suh Y, Hong H, Ohana M, et al. Pulmonary Embolism and Deep Vein Thrombosis in COVID-19: A Systematic Review and Meta-Analysis. Radiology. 2021; 298(2): E70-E80. https://doi.org/10.1148/radiol.2020203557. |
| [4] | Moores L. Don't Do Anything! Just Stand There! Chest. 2021; 159(3): 9089. https://doi.org/10.1016/j.chest.2020.12.022. |
| [5] | Berger J, Kunichoff D, Adhikari S, et al. Prevalence and Outcomes of D-Dimer Elevation in Hospitalized Patients With COVID-19. Arteriosclerosis, Thrombosis, And Vascular Biology. 2020; 40(10): 2539-47. https://doi.org/10.1161/atvbaha.120.314872. |
| [6] | Tsaplin S, Schastlivtsev I, Zhuravlev S, et al. The original and modified Caprini score equally predicts venous thromboembolism in COVID-19 patients. J Vasc Surg Venous Lymphat Disord. 2021; 9(6): 1371-81. e4. https://doi.org/10.1016/j.jvsv.2021.02.018. |
| [7] | Lobastov K, Schastlivtsev I, Tsaplin S, et al. Prediction of Symptomatic Venous Thromboembolism in Covid-19 Patients: A Retrospective Comparison of Caprini, Padua, and IMPROVE-DD Scores. J Vasc Surg Venous Lymphat Disord. 2022; 10(2): 572-3. https://doi.org/10.1016/j.jvsv.2021.12.062. |
| [8] | Thachil J, Tang N, Gando S, et al. ISTH interim guidance on recognition and management of coagulopathy in COVID-19. J Thromb Haemost. 2020; 1 8(5):1 023-6. https://doi.org/10.1111/jth.14810. |
| [9] | Barnes G, Burnett A, Allen A, et al. Thromboembolism and anticoagulant therapy during the COVID-19 pandemic: interim clinical guidance from the an-ticoagulation forum. J Thromb Thrombolysis. 2020; 50(1): 72-81. https://doi.org/10.1007/s11239-020-02138-z. |
| [10] | Lobastov K.V., Stepanov E.A., Tsaplin S.N., etc. Efficacy and safety of increased doses of anticoagulants in patients with COVID-19: results of a systematic literature review and meta-analysis. Surgeon. 2022; (1-2): 50-65. |
| [11] | Lopes RD, de Barros e Silva PGM, Furtado RHM, et al. Therapeutic ver-sus prophylactic anticoagulation for patients admitted to hospital with COVID-19 and elevated D-dimer concentration (ACTION): an open-label, multi-centre, randomized, controlled trial. Lancet. 2021; 397(10291): 2253-63. https://doi.org/10.1016/S0140-6736(21)01203. |